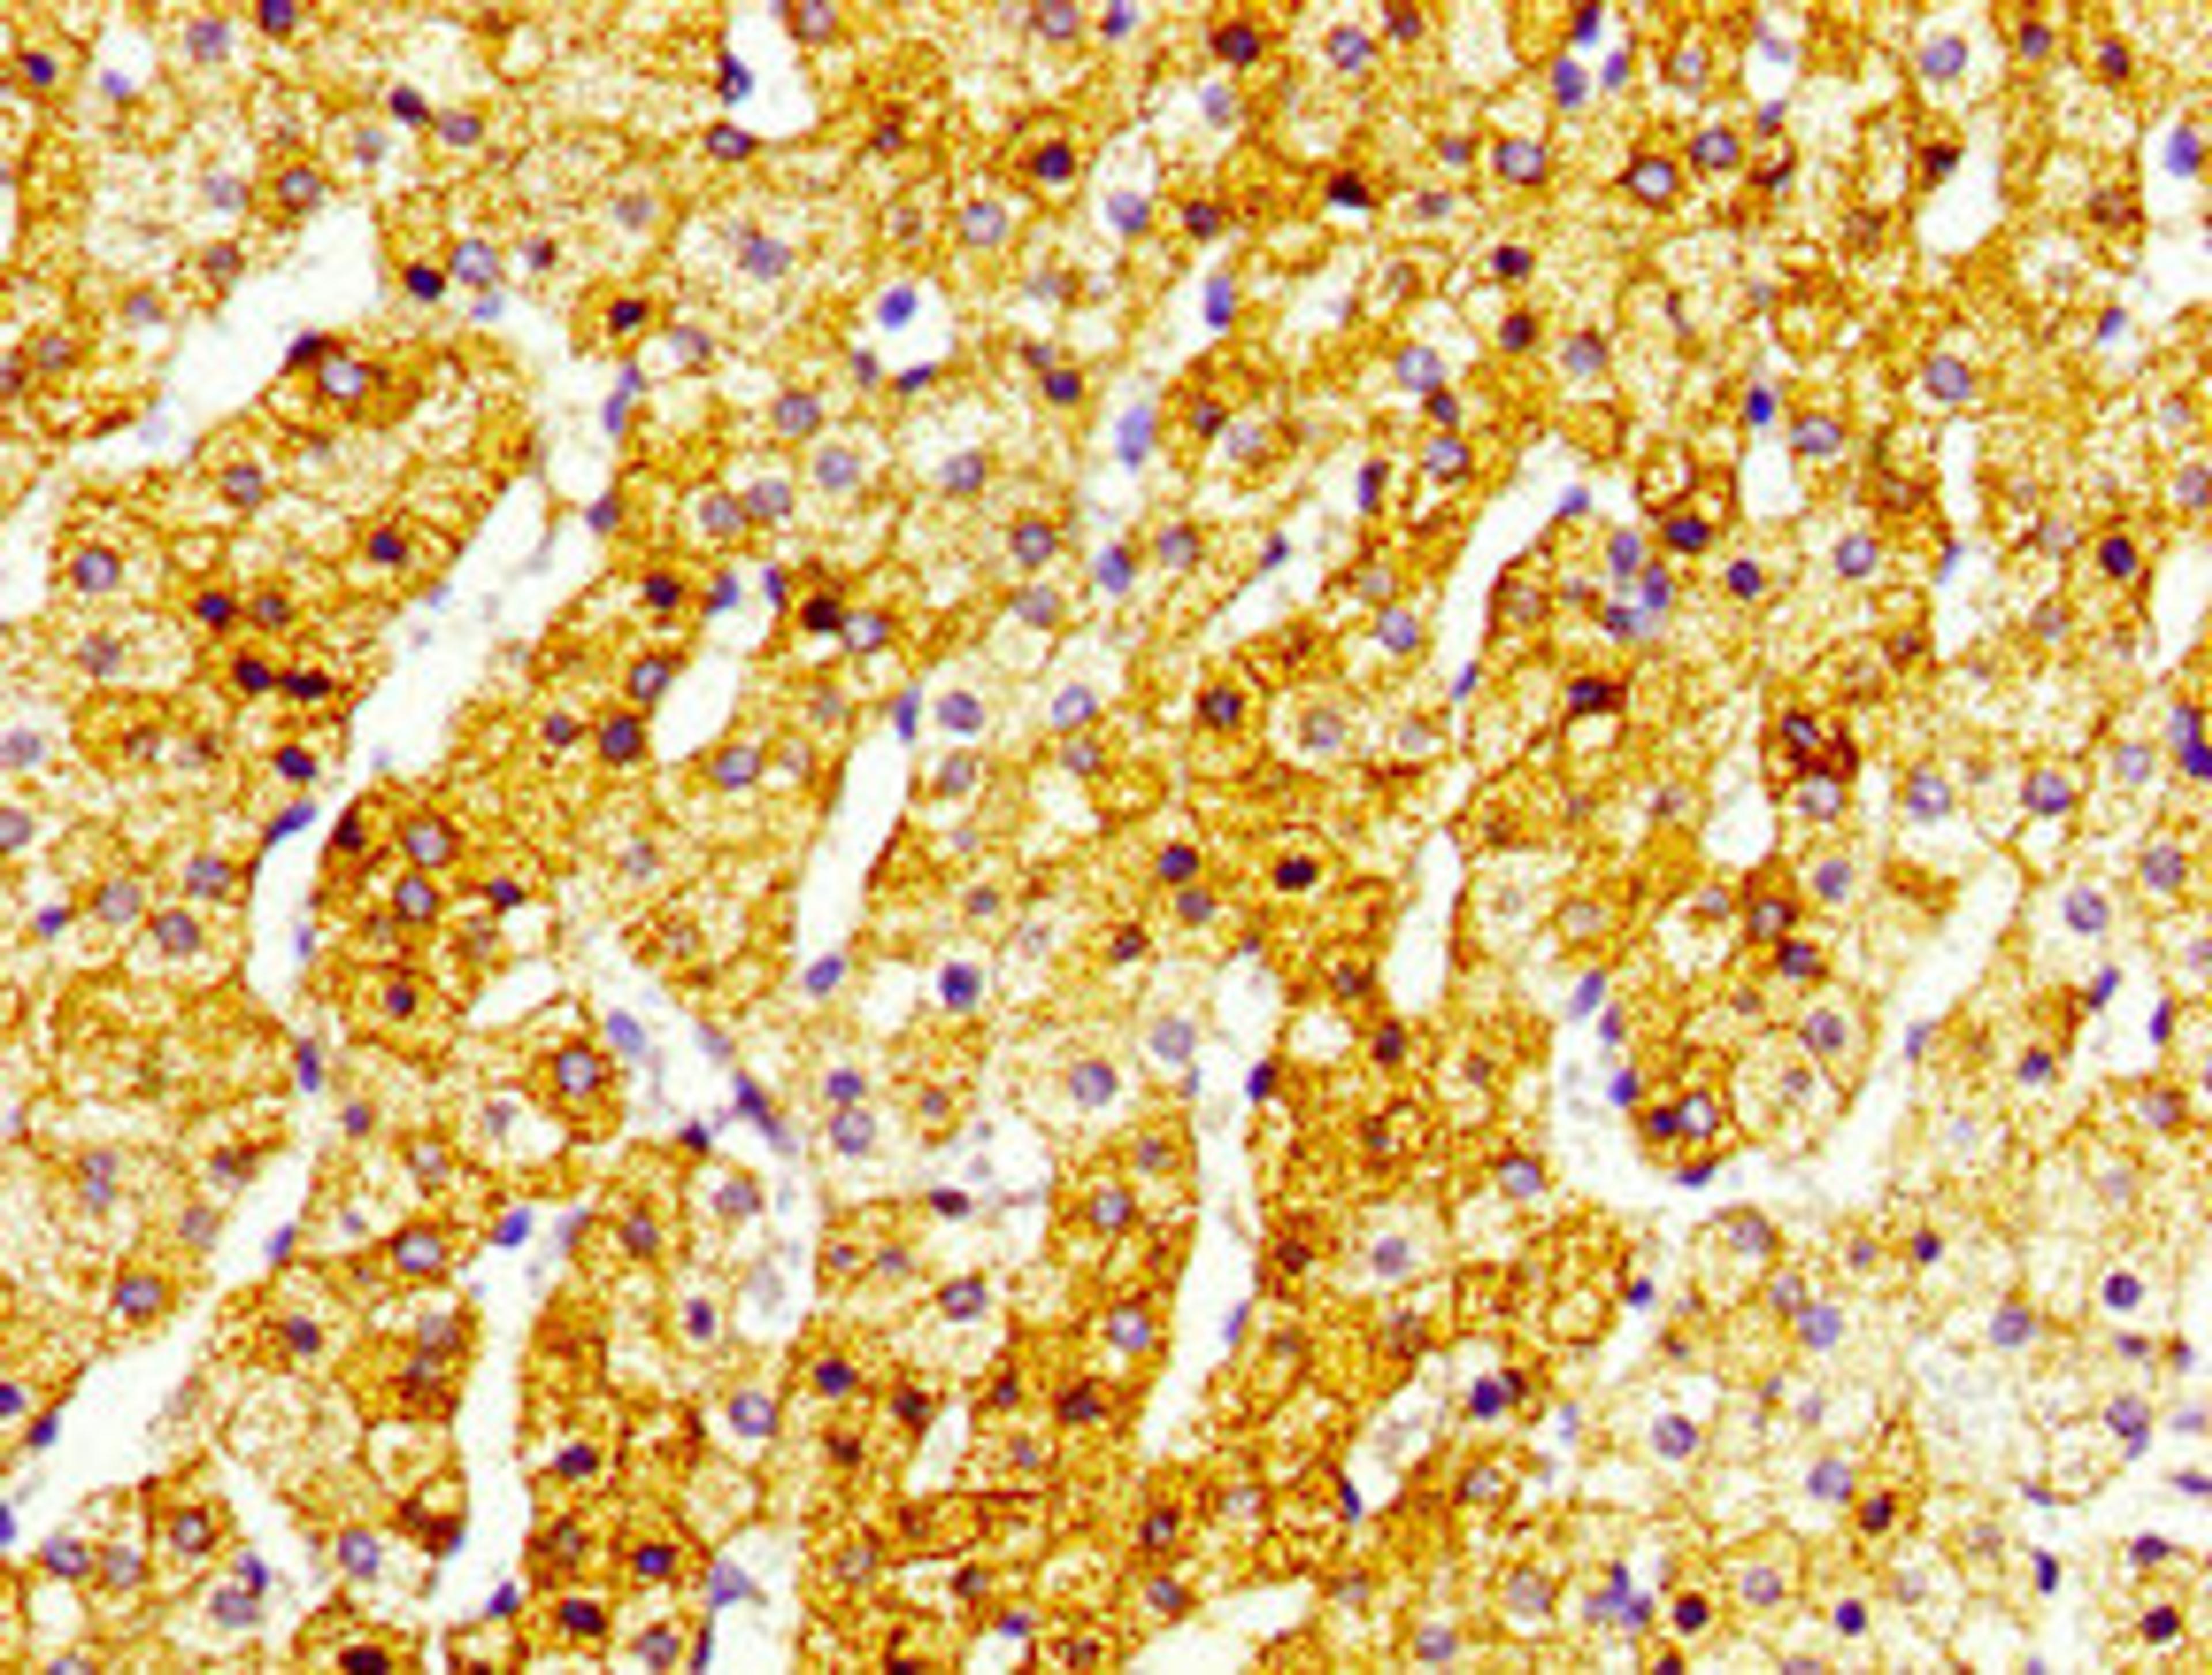
Immunohistochemistry of paraffin-embedded human adrenal gland tissue using CSB-PA873680LA01HU at dilution of 1:100

CF®543 Goat Anti-Rabbit IgG (H+L), Highly Cross-Adsorbed, 2mg/mL
- Manufacturer
- Biotium
- Catalog Number
- #20300
- Host
- Goat
- Applications
- Immunofluorescence, Immunohistochemistry (Formalin-Fixed Sections), Immunohistochemistry (Frozen Sections), Western Blotting